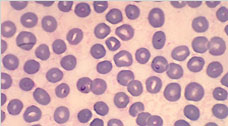

-

Lyme Disease
Lyme disease is caused by the bacterium Borrelia burgdorferi and is transmitted to humans through the bite of infected blacklegged ticks. Typical symptoms include fever, headache, fatigue, and a characteristic skin rash called erythema migrans (EM). If left untreated, infection can spread to joints, the heart, and the nervous system.
Lyme disease is diagnosed based on symptoms, physical findings (e.g., rash), laboratory tests, and the possibility of exposure to infected ticks. Many cases of Lyme disease can be treated successfully with antibiotics. The ticks that transmit Lyme disease can occasionally transmit other tickborne diseases as well.
-
Babesiosis
Babesiosis is caused by microscopic parasites that infect red blood cells and are spread by certain ticks. In the United States, tickborne transmission is most common in particular regions and seasons: it mainly occurs in parts of the Northeast and upper Midwest and usually peaks during the warm months.
Although many people who are infected with Babesia do not have symptoms, effective treatment is available for those who do. Babesia microti is transmitted by the bite of infected Ixodes scapularis ticks—typically, by the nymph stage of the tick, which is about the size of a poppy seed.
-

Anaplasmosis
Anaplasmosis is a tickborne disease caused by the bacterium Anaplasma phagocytophilum. It was previously known as human granulocytic ehrlichiosis (HGE) and has more recently been called human granulocytic anaplasmosis (HGA).
Anaplasmosis is transmitted to humans by tick bites primarily from the black-legged tick (Ixodes scapularis) and the western black-legged tick (Ixodes pacificus). Of the four distinct phases in the tick life-cycle (egg, larvae, nymph, adult), nymphal and adult ticks are most frequently associated with transmission of anaplasmosis to humans. Typical symptoms include: fever, headache, chills, and muscle aches. Usually, these symptoms occur within 1-2 weeks of a tick bite.
-

Other Diseases Include:
- Ehrlichiosis
- Rickettsiosis
- Rocky Mountain Spotted Fever (RMSF) & Other Spotted Fevers
- Southern Tick-Associated Rash Illness (STARI)
- Tickborne Relapsing Fever (TBRF)
- Tularemia
Tickborne diseases have become a serious health problem in many parts of North America. This is due in part to more homes being built in formerly uninhabited wilderness areas where ticks and their animal hosts live and because of the many activities that people enjoy outdoors in areas with ticks.
Tickborne diseases can be caused by viruses, bacteria or parasites. They include the following:

